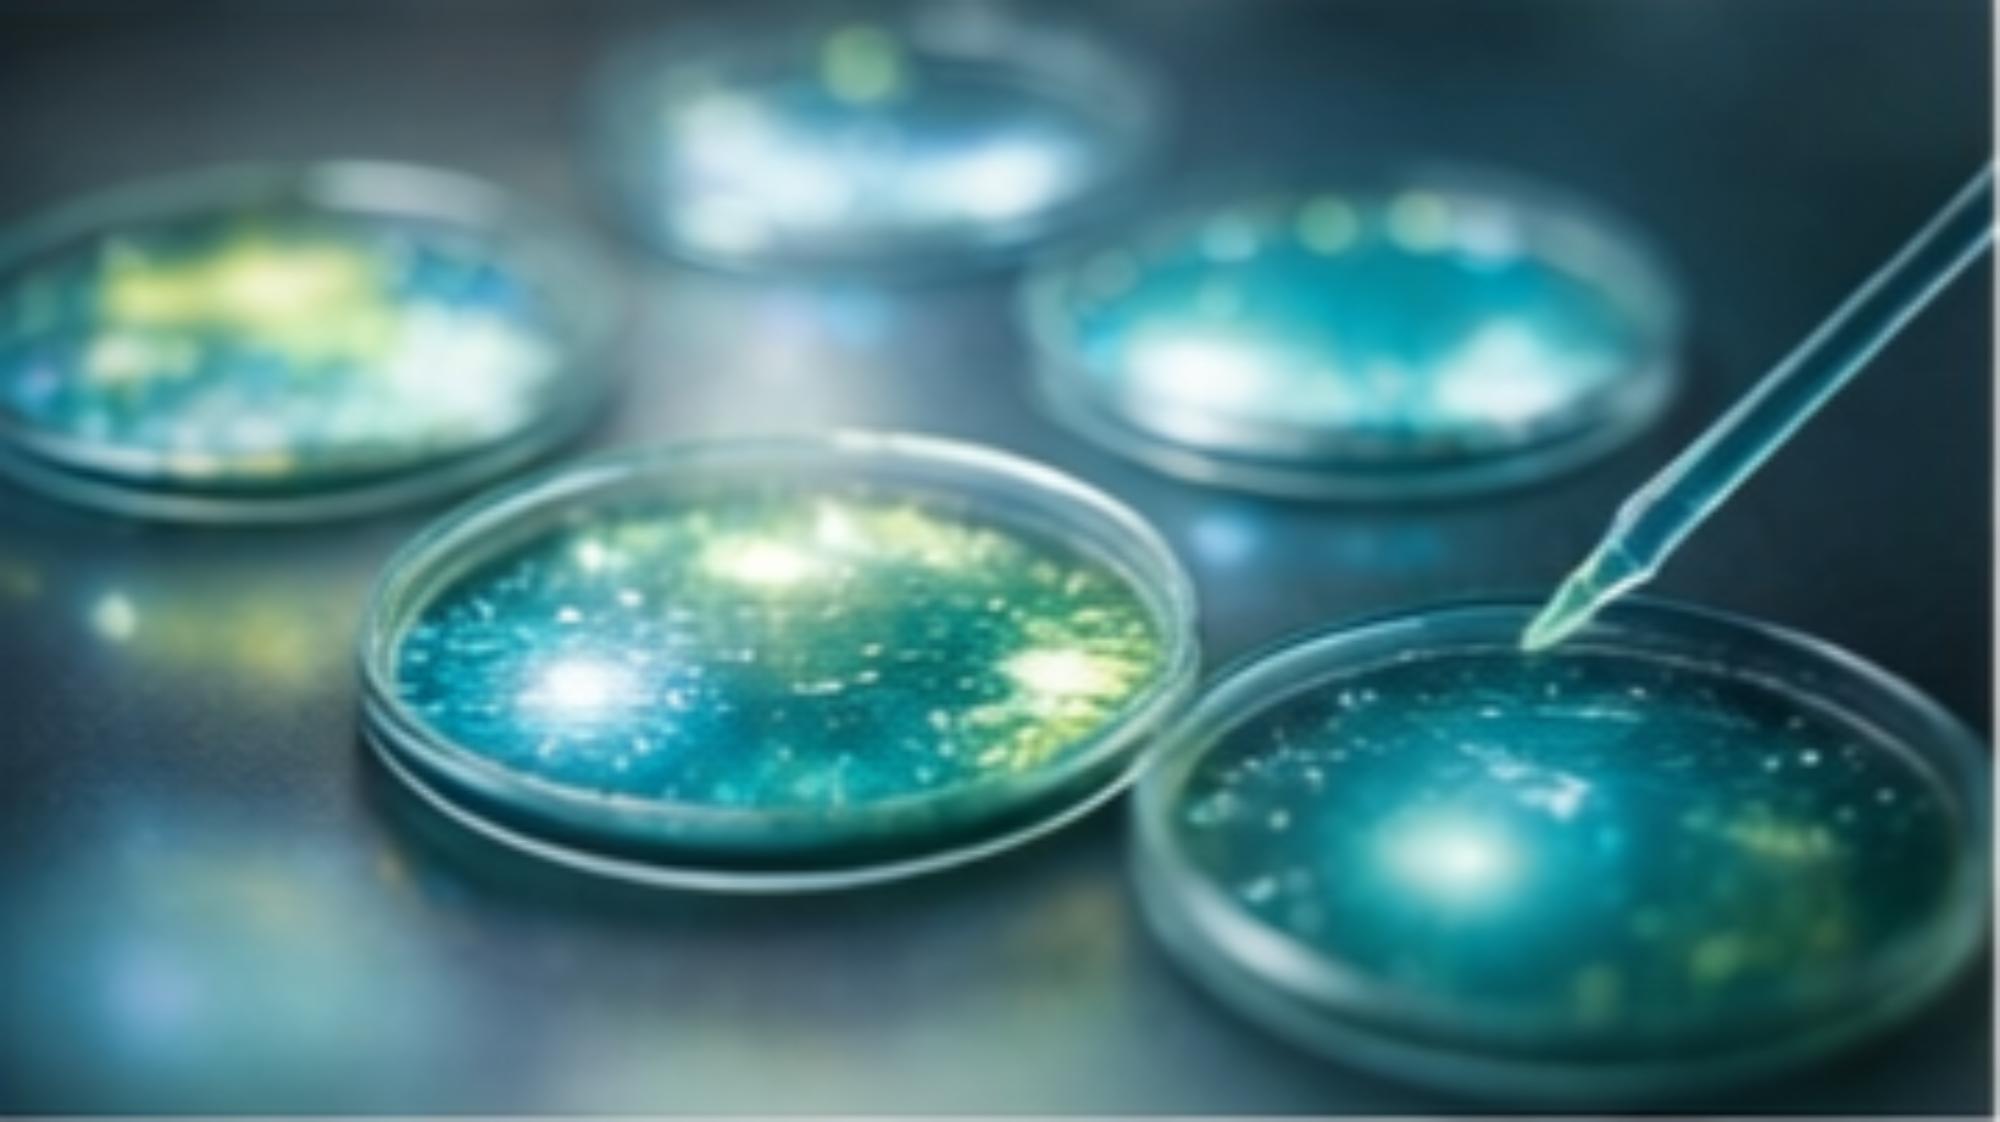

Con la inmunoterapia todos ganamos
Ponencia para clínicas veterinarias: inmunoterapia en dermatología. Beneficios, objeciones, seguimiento e implantación para mejorar adherencia y resultados.
De qué va
La inmunoterapia es una oportunidad clínica y relacional: mejora el control a largo plazo, reduce dependencia de fármacos sintomáticos y crea un marco de seguimiento que fideliza. Esta ponencia ordena el discurso y la implantación práctica para que el tutor entienda el porqué, el cómo y el cuándo.
Lo que ganan los pacientes
- Reducción de prurito e irritación; menos lesiones e infecciones secundarias.
- Mejora de salud general y calidad de vida (confort, bienestar, interacción social).
- Menos necesidad de medicación sintomática y sus efectos adversos a largo plazo.
Lo que ganan los tutores
- Más control proactivo de la enfermedad y menos cambios constantes de estrategia.
- Tranquilidad: sienten que están abordando la causa y no solo el síntoma.
- Reducción de costes a largo plazo al disminuir urgencias y medicación diaria.
Lo que gana la clínica
- Tratamientos efectivos y solución duradera para casos crónicos complejos.
- Desarrollo profesional y especialización.
- Fidelización: relación duradera por seguimiento; reputación como referente.
- Oportunidades: planes de salud, venta cruzada y campañas educativas.
El gran desafío: persuadir sin presionar
Explicar simplicidad de pruebas y comodidad frente a brotes repetidos.
Identificar alérgenos, personalizar tratamiento y evitar ensayo-error.
Eficiencia y coste acumulado: el objetivo es control sostenido.
Coste inicial, tiempo para resultados, incertidumbre de eficacia, efectos secundarios y compromiso.
Si las pruebas salen negativas
Un negativo no es un fracaso: es información que descarta alérgenos y reorienta el diagnóstico. La clave es gestión emocional, reenfocar el resultado y proponer alternativas con un plan claro.
Mitos y realidades
- Formación y complejidad del proceso: cómo simplificar protocolos internos.
- Costes y rentabilidad: cómo explicarlo sin “defenderse”.
- Tiempo y variabilidad de respuesta: gestionar expectativas y seguimiento.
Estructura (formato recomendado)
Beneficios por actor: paciente, tutor y clínica.
Pruebas, personalización, comparación a largo plazo, casos y testimonios.
Guion práctico para coste, tiempos, efectividad, efectos secundarios y compromiso.
Negativos, frustración y cómo mantener la relación y el plan.
Seguimiento, materiales, comunicación interna y próximo paso.
Entregables
- Mapa de beneficios (paciente / tutor / clínica) para explicar en consulta.
- Guion de objeciones + frases puente.
- Checklist de seguimiento para que el tutor no se sienta “solo”.
- Propuesta de campaña educativa (redes + sala de espera) orientada a confianza.
Ponencia basada en material formativo: Jordi Serarols Tort y Xavier Serra Fabregat.
¿Lo adaptamos a tu realidad?
Ajustamos duración, ejemplos y nivel práctico a vuestro servicio. La idea no es “dar una charla”. Es dejar un marco de conversación y un sistema de seguimiento que funcione.